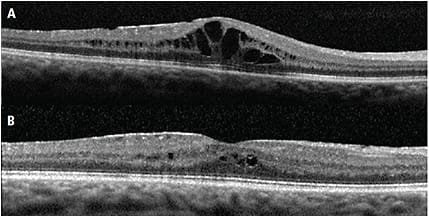
Irvine Gass

Catégorie : Ophtalmologie générale
-

PKT : la photo-kératectomie thérapeutique au laser excimer
PKT : la photo-kératectomie thérapeutique au laser excimer La PKT (Photo-Kératectomie Thérapeutique) — appelée PTK en anglais (PhotoTherapeutic Keratectomy) — est une technique de laser excimer thérapeutique qui traite certaines pathologies cornéennes superficielles en réalisant une ablation contrôlée de la couche superficielle de la cornée. Contrairement à la PKR réfractive qui sculpte la cornée pour…
-

Chirurgie réfractive du militaire
Chirurgie réfractive du militaire à Toulon : aptitudes, réglementation et techniques La chirurgie réfractive chez le militaire est aujourd’hui largement pratiquée et acceptée dans les armées françaises, sous réserve du respect d’un cadre réglementaire précis défini par le profil médical SIGYCOP et par les arrêtés ministériels propres à chaque armée. À Toulon, premier port militaire…
-
Œdème maculaire d’Irvine-Gass : la complication post-cataracte à connaître
Œdème maculaire d’Irvine-Gass : la complication post-cataracte à connaître Le syndrome d’Irvine-Gass (aussi appelé œdème maculaire cystoïde pseudophake) est une complication post-opératoire de la chirurgie de la cataracte qui se traduit par un œdème de la macula (la zone centrale de la rétine), apparaissant typiquement 4 à 12 semaines après l’opération. La fréquence cliniquement significative…
-

Implants Add-On Piggy-Back : un deuxième implant pour ajuster la vision
Implants Add-On Piggy-Back : un deuxième implant pour ajuster la vision L’implant Add-On Piggy-Back est une solution ingénieuse pour ajuster la vision chez un patient déjà pseudophaque (porteur d’un implant intraoculaire après chirurgie de la cataracte) : au lieu d’extraire l’implant existant — chirurgie complexe sur sac fibreux —, on ajoute un deuxième implant dans…
-

Corriger la presbytie : laser ou implant intraoculaire ?
Corriger la presbytie : laser ou implant intraoculaire ? La presbytie touche tous les humains à partir de 40-45 ans : c’est la perte progressive de l’accommodation, cette capacité du cristallin à modifier sa courbure pour faire la mise au point sur les objets proches. Quand les lunettes de lecture deviennent encombrantes ou que les…
-

L’intelligence artificielle en chirurgie réfractive et de la cataracte
L’intelligence artificielle en chirurgie réfractive et de la cataracte L’intelligence artificielle (IA) est aujourd’hui une réalité concrète dans la pratique ophtalmologique moderne — et particulièrement en chirurgie réfractive et de la cataracte. Loin du fantasme de la machine remplaçant le chirurgien, l’IA est avant tout un outil d’aide à la décision et de précision diagnostique…
-

Nouveaux implants multifocaux 2025 : panorama des dernières générations
Nouveaux implants multifocaux 2025 à Toulon : panorama des dernières générations d’implants premium Les implants intraoculaires premium ont connu une évolution spectaculaire ces cinq dernières années. Les compromis classiques des multifocaux diffractifs (halos nocturnes marqués, baisse de contraste, perte lumineuse) se sont nettement atténués grâce à plusieurs ruptures technologiques majeures : trifocaux à haute utilisation…
-

Arnaques en chirurgie ophtalmologique : reconnaître les pièges
Arnaques en chirurgie ophtalmologique : reconnaître les pratiques douteuses Le succès de la chirurgie réfractive et de la chirurgie de la cataracte premium attire malheureusement des pratiques douteuses : cliniques low-cost à l’étranger aux résultats parfois catastrophiques, démarchage commercial agressif, prix d’appel trompeurs, chirurgiens insuffisamment qualifiés, absence de suivi post-opératoire. Plusieurs reportages télévisés récents (M6,…
-

Collyre pour la presbytie : la révolution Vuity® et au-delà
Collyre pour la presbytie : la révolution Vuity® et au-delà Depuis 2021 et l’autorisation par la Food and Drug Administration aux États-Unis du Vuity® (pilocarpine 1,25 %), une nouvelle classe thérapeutique a vu le jour : les collyres pour la presbytie. Ces gouttes promettent de réduire — temporairement — la dépendance aux lunettes de lecture…
-

Dysphotopsies après cataracte : halos, glare et croissant temporal
Dysphotopsies après cataracte : halos, glare et croissant temporal Les dysphotopsies sont des phénomènes visuels indésirables qui peuvent survenir après une chirurgie de la cataracte avec pose d’un implant intraoculaire. On distingue deux grands types : les dysphotopsies positives (halos, anneaux concentriques, glare, traînées lumineuses autour des phares) et les dysphotopsies négatives (croissant ou ombre…
